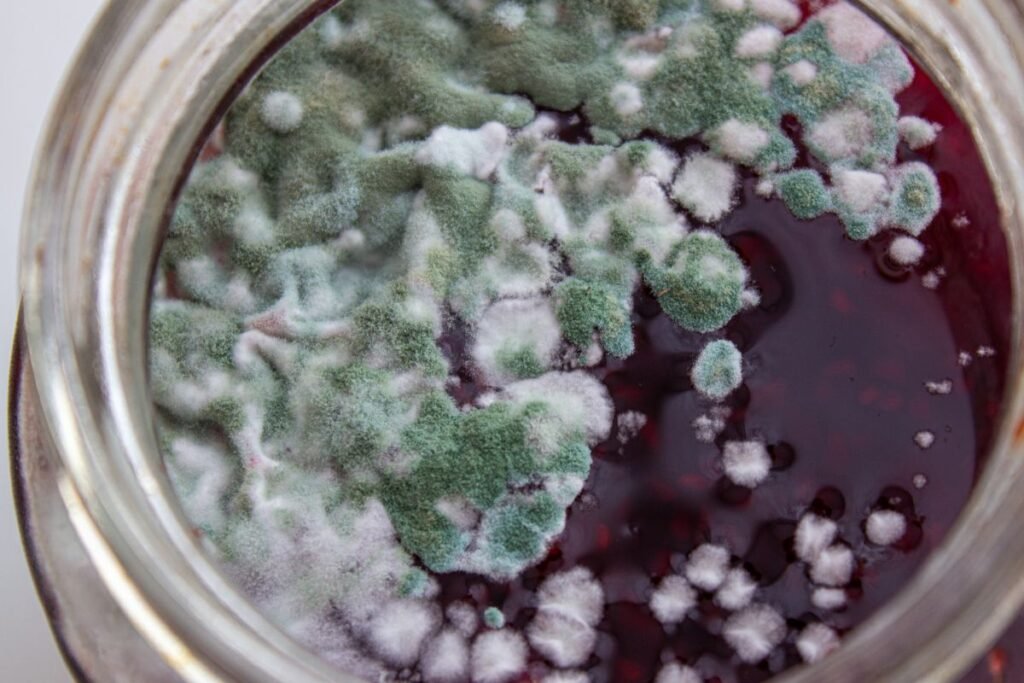
Kaip apsaugoti uogienę nuo pelėsio

Atidarius uogienės stiklainį ir aptikus paviršiuje balsvą ar žalsvą apnašą, daugelis iš mūsų susiduria su dilema – ar sugadinta visa uogienė, ar galima tiesiog nugriebti pelėsį ir toliau mėgautis skanėstu? Pelėsis ant uogienės – dažna problema, su kuria susiduria net patys atidžiausi šeimininkai. Svarbu suprasti, kodėl jis atsiranda ir ar tokią uogienę vis dar saugu vartoti.
Kodėl susidaro pelėsis ant uogienės?
Pelėsis – tai mikroskopinių grybų kolonijos, kurios vystosi esant tam tikroms sąlygoms. Net kruopščiai pagaminta uogienė gali imti pelyti, jei susidaro tinkamos šių mikroorganizmų dauginimosi aplinkybės.
Pagrindinė priežastis – nepakankamas cukraus kiekis. Cukrus veikia kaip natūralus konservantas, trukdantis mikroorganizmams daugintis. Jei uogienė gaminama siekiant sumažinti kaloringumą ir cukraus dedama mažiau nei rekomenduojama (paprastai santykis turėtų būti 1:1 arba bent 60–70 % cukraus nuo bendros masės), konservantų savybės susilpnėja. Tokioje aplinkoje pelėsio sporos lengvai gali pradėti dygti.
Antra dažna priežastis – drėgmė. Jei uogienė nepakankamai ilgai virta, joje lieka per daug skysčio. Drėgna aplinka yra ideali pelėsiui augti. Taip pat pelėsis gali atsirasti, jei stiklainiai buvo netinkamai užsandarinti arba virš uogienės susikaupė kondensuotas garas.
Trečia problema – sterilumo pažeidimas. Nesterilizuoti stiklainiai, neišvirinti dangteliai arba nešvarūs įrankiai, kuriais uogienė imama iš stiklainio, gali įnešti pelėsio sporas. Net viena pelėsio spora tinkamomis sąlygomis gali pradėti augti ir per kelias dienas apaugti didelę paviršiaus dalį.

Pelėsis ant uogienės: ar dar saugu valgyti?
Daugelis žmonių mano, kad pakanka nugrėbti pelėsį, o likusią uogienę galima ramiai valgyti. Deja, tai pavojingas mitas. Pelėsis, kurį matome paviršiuje, yra tik matoma pelėsio dalis – vadinamieji trofai ir sporangai. Tačiau pelėsio grybelis turi ir nematomą dalį – hifų tinklą, kuris įsiskverbia gilyn į produktą.
Kai kurie pelėsio grybeliai gamina mikotoksinus – nuodingus junginius, kurie gali pakenkti kepenims, inkstams ir imuninei sistemai. Šie toksinai yra atsparūs temperatūrai, todėl net pakartotinis virimas nepadeda jų sunaikinti. Ypač pavojingi yra aflatoksinai, kurie laikui bėgant gali sukelti sunkių sveikatos sutrikimų.
Rekomenduojamas video
Todėl mitybos specialistai ir maisto saugos ekspertai vieningai rekomenduoja: jei ant uogienės atsirado pelėsis, visą stiklainio turinį reikia išmesti. Rizika sveikatai nėra verta kelių dešimčių gramų uogienės.
Kaip apsaugoti uogienę nuo pelėsio
Norint, kad namuose pagaminta uogienė išliktų saugi ir skani visą žiemą, svarbu laikytis kelių paprastų, bet svarbių taisyklių:
- Pirmiausia – tiksliai laikykitės recepto. Jei nurodyta dėti kilogramą cukraus, nederėtų jo kiekio mažinti, net jei atrodo, kad uogienė bus per saldi. Cukrus čia atlieka ne tik skonį formuojančią, bet ir konservuojančią funkciją. Tinkamas santykis – mažiausiai 500–600 g cukraus vienam kilogramui uogų.
- Antra – tinkamai išvirkite uogienę. Ji turi būti verdama tol, kol masė sutirštėja. Paprastas testas: lašas uogienės, užvarvintas ant šaltos lėkštės, neturėtų tekėti. Gerai išvirta uogienė yra tirštos konsistencijos, kuri neleidžia pelėsiui lengvai vystytis.
- Trečia – sterilumas. Stiklainius būtina sterilizuoti verdančiame vandenyje arba orkaitėje. Dangtelius taip pat reikia išvirinti. Supilstykite uogienę į karštus stiklainius ir iš karto užsukite dangtelius. Tokiu būdu sukuriamas vakuumas, kuris apsaugo nuo mikroorganizmų patekimo.
- Ketvirta – tinkamas laikymas. Uždaryti uogienės stiklainiai turėtų būti laikomi vėsioje, sausoje, tamsoje vietoje. Ideali temperatūra – apie 10–15 laipsnių. Atidaryta uogienė turi būti laikoma šaldytuve ir suvartojama per 2–3 savaites. Svarbiausia taisyklė – niekada neimkite uogienės drėgnais ar nešvariais šaukštais, nes taip galite užkrėsti visą turinį.
Pelėsis ant uogienės: papildomi apsaugos būdai
Kai kurie šeimininkai ant paruoštos uogienės, prieš uždengdami dangteliu, užpila ploną sluoksnį alkoholio (konjako arba romo). Garuojantis alkoholis sukuria papildomą apsaugą nuo pelėsio. Kiti ant uogienės paviršiaus deda specialų cukraus diskelį arba tiesiog užberia storoku cukraus sluoksniu – jis absorbuoja drėgmę ir neleidžia pelėsiui vystytis.
Svarbu atminti, kad net geriausiai pagaminta uogienė turi tinkamo galiojimo laiką. Paprastai namų gamybos uogienes rekomenduojama laikyti ne ilgiau kaip 12–18 mėnesių. Po šio laikotarpio net nesupelėjusi uogienė gali prarasti maistinę vertę ir skonį.
Pelėsis ant uogienės – ne tik estetinė, bet ir saugumo problema. Geriau skirti daugiau dėmesio tinkamam paruošimui nei vėliau rizikuoti sveikata. O aptikus apipelijusį produktą, saugiausia jį išmesti ir kitą kartą pasistengti laikytis visų konservavimo reikalavimų.
Šaltiniai:
- https://www.healthycanning.com/mould-home-preserves/
- https://www.bbc.com/news/uk-47227477
- https://blog.thenibble.com/2013/09/17/tip-of-the-day-mold-in-jelly-jam/
Nuotraukos asociatyvinės © Canva.

Pelėsis ant uogienės – išties rimta problema, kuriai reiketu skirti daugiau dėmesio!
Kai pamatau pelėsį ant uogienės, visad išmetu. Neverta rizikuoti sveikata.
Oj, vel pelėsis ant uogienės! Reiks viską išmest, nesaugu valgyt.
Na, man tai atrodo, kad kartais tikrai galima nugriebti pelėsį. Ne visada viską reikia išmest.
nežinau kaip galima išgauti pelėsio uogienėję? Išvirti, supilti į stiklainį IKI VIRŠAUS IR UŽSUKI DANGTELĮ.jokio pelėsio nebus jei įpylsi uogienę kad išbėgtu per kraštus ir tada dedi dangtelį.Stiklainių nekaltinu išplauna su įndų plovikliu
Na jau ne esu jauna-visą gyvenimą pasitaikydavo, kad kur nors atsirasdavo pelėsis-nugriebdavau maždaug iki pusės stiklainio uogienę ir pervirdavau.